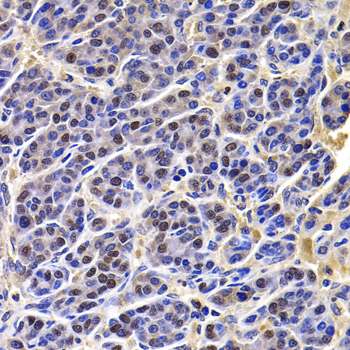
A7014: image 4
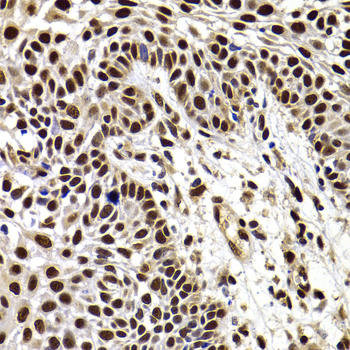
A7014: image 6

For quotations, please use our online quotation form, and you may also contact us by
service@kendallscientific.com
+1-888.733.6849 (Toll-free)
+1-617.299.7367 (Int’l))
+1-888.733.6849
Our customer service representatives are available 24 hours, Monday through Friday to assist you.| Reactivity | Human Mouse Rat |
| Tested applications | WB IHC IF |
| Recommended Dilution | WB 1:500 - 1:2000 IHC 1:50 - 1:200 IF 1:50 - 1:100 |
| Calculated MW | 62kDa |
| Observed MW | Refer to figures |
| Immunogen | Recombinant protein of human HIRIP3 |
| Storage Buffer | Store at -20℃. Avoid freeze / thaw cycles. Buffer: PBS with 0.02% sodium azide, 50% glycerol, pH7.3. |

Western blot analysis of extracts of various cell lines, using HIRIP3 antibody.

Immunohistochemistry of paraffin-embedded rat liver using HIRIP3 antibody at dilution of 1:100 (x400 lens).

Immunohistochemistry of paraffin-embedded rat spleen using HIRIP3 antibody at dilution of 1:100 (x400 lens).
Immunohistochemistry of paraffin-embedded human liver cancer using HIRIP3 antibody at dilution of 1:100 (x400 lens).

Immunohistochemistry of paraffin-embedded human oophoroma using HIRIP3 antibody at dilution of 1:100 (x400 lens).
Immunohistochemistry of paraffin-embedded human well-differentiated squamous skin carcinoma using HIRIP3 antibody at dilution of 1:100 (x400 lens).

Immunohistochemistry of paraffin-embedded human kidney using HIRIP3 antibody at dilution of 1:100 (x400 lens).

Immunohistochemistry of paraffin-embedded human kidney cancer using HIRIP3 antibody at dilution of 1:100 (x400 lens).

Immunohistochemistry of paraffin-embedded mouse liver using HIRIP3 antibody at dilution of 1:100 (x400 lens).

Immunohistochemistry of paraffin-embedded mouse kidney using HIRIP3 antibody at dilution of 1:100 (x400 lens).

Immunofluorescence analysis of U20S cell using HIRIP3 antibody.
The HIRA protein shares sequence similarity with Hir1p and Hir2p, the two corepressors of histone gene transcription characterized in the yeast, Saccharomyces cerevisiae. The structural features of the HIRA protein suggest that it may function as part of a multiprotein complex. Several cDNAs encoding HIRA-interacting proteins, or HIRIPs, have been identified. In vitro, the protein encoded by this gene binds HIRA, as well as H2B and H3 core histones, indicating that a complex containing HIRA-HIRIP3 could function in some aspects of chromatin and histone metabolism. Alternatively spliced transcript variants encoding distinct isoforms have been found for this gene.
N/A